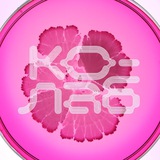

Media is too big
VIEW IN TELEGRAM
Сперва роди: есть ли идеальное время для рождения детей?
Темой свежего выпуска БЕЗФИЛЬТРОВ Анастасии Полетаевой, журналиста и партнера «Ко-Лаб», стал феномен отложенного материнства – насколько социум влияет на репродуктивное поведение женщин, какие риски влечет более позднее материнство и какие у него плюсы.
Социальный тренд усиливается: неуверенность в завтрашнем дне, социо-психологические и экономические причины вынуждают многих женщин отложить рождение ребенка (иногда это выбор, иногда это вынужденная мера). В современном мире, где мы планируем отпуска на год вперед, эксперты настаивают: беременность тоже нужно планировать, а это значит – следить за своим репродуктивным здоровьем.
Героинями БЕЗФИЛЬТРОВ стали женщины с разным опытом — от естественной беременности до диагностированного бесплодия, ЭКО и услуг суррогатной матери. В выпуске также есть история с не самым широко известным диагнозом «вторичное бесплодие» — когда женщина не может зачать ребенка после одной и более успешных беременностей. Своей историей поделилась блогер Наталья Турецкая: ей пришлось пройти через процедуру ЭКО, которая завершилась абортом по медицинским показателям, что вызвало волну хейта в сторону Натальи. Но она не оставила попыток завести третьего ребенка и обратилась к услугам суррогатной матери.
Героинями выпуска также стали инфлюенсер Мария Тарасова, основательница медиа о женском здоровье Reya Татьяна Печурко и Ольга Пивень , основательница ЦИПРа и соосновательница «Ко-Лаб».
Темой свежего выпуска БЕЗФИЛЬТРОВ Анастасии Полетаевой, журналиста и партнера «Ко-Лаб», стал феномен отложенного материнства – насколько социум влияет на репродуктивное поведение женщин, какие риски влечет более позднее материнство и какие у него плюсы.
Социальный тренд усиливается: неуверенность в завтрашнем дне, социо-психологические и экономические причины вынуждают многих женщин отложить рождение ребенка (иногда это выбор, иногда это вынужденная мера). В современном мире, где мы планируем отпуска на год вперед, эксперты настаивают: беременность тоже нужно планировать, а это значит – следить за своим репродуктивным здоровьем.
«Социуму все время кажется, что интеллект может победить абсолютно все. С точки зрения биологии самые насыщенные репродуктивные годы — от 18 до 28 лет. Далее идет снижение репродуктивного потенциала женщины. Истории из соцсетей о том, как кто-то с легкостью стал матерью в 43-45 – это скорее исключение из правила, которое его только подтверждают», – говорит Вера Коренная, главный гинеколог Департамента здравоохранения города Москва и заместитель директора МКНИЦ «Больница 52».
«Наше физическое состояние, связанное с увеличением продолжительности жизни и образом жизни, нас путает: оно говорит нам о том, что у нас все впереди и что мы молоды и прекрасны, а генетика не может меняться так быстро. Наша репродуктивная тема создана эволюцией. Это гены. Они не меняются с такой скоростью. Поэтому репродуктивный возраст, к сожалению, не продлевается», — отмечает Галина Филиппова, доктор психологических наук, профессор, ректор Института перинатальной и репродуктивной психологии.
Героинями БЕЗФИЛЬТРОВ стали женщины с разным опытом — от естественной беременности до диагностированного бесплодия, ЭКО и услуг суррогатной матери. В выпуске также есть история с не самым широко известным диагнозом «вторичное бесплодие» — когда женщина не может зачать ребенка после одной и более успешных беременностей. Своей историей поделилась блогер Наталья Турецкая: ей пришлось пройти через процедуру ЭКО, которая завершилась абортом по медицинским показателям, что вызвало волну хейта в сторону Натальи. Но она не оставила попыток завести третьего ребенка и обратилась к услугам суррогатной матери.
Героинями выпуска также стали инфлюенсер Мария Тарасова, основательница медиа о женском здоровье Reya Татьяна Печурко и Ольга Пивень , основательница ЦИПРа и соосновательница «Ко-Лаб».
❤13
«Мне 40, жизнь кончена». Какая чушь!»
Эту неделю посвятим теме долголетия. Начинаем с нашего регулярного дайджеста инфоповодов, а также разберем, почему понятие «цикл жизни» уходит в прошлое, может ли биохакинг помочь предотвратить старение – и как нашему стремлению к молодости мешает ежедневный стресс.
1. Тренд на longevity (ставший главным в 2025 году по версии BoF) в следующем году будет только набирать обороты.
Акцент сместился с lifespan (цикл жизни) на healthspan (цикл здоровья) – годы, свободные от слабостей и болезней. Новая роскошь – это не дорогие вещи, а доступ к самой качественной медицине и новым технологиям.
Так, например, только в США замедление процесса старения для увеличения ожидаемой продолжительности жизни на один год в сочетании со снижением заболеваемости принесет экономике $38 трлн.
2. На тренд активного долголетия отвечают и соцсети, в которых все чаще героями становятся пожилые люди. Так, 77-летняя Барбара «Babs» Костелло стала «любимой бабушкой TikTok»: у нее в подписчиках больше 8 млн человек. Она начала пользоваться соцсетями только в 72 года, а теперь ведет аккаунт, в котором делится бытовыми советами и философией здоровой зрелости: «Люди думают: "Мне 40, жизнь кончена". Какая чушь».
3. 55-летний биолог Гэри Брекка утверждает, биологический возраст можно изменить в лучшую сторону не только с помощью биохакинга, а привычным зожем. По его словам, его биологический возраст соответствует показателям 20-летнего человека. Формула Бреккка:
Исследования, конечно, подтверждают влияние такого образа жизни на маркеры биологического возраста, но откатить возраст до молодости таким образом на самом деле вряд ли возможно(как и минимизировать стресс) .
4. В подкасте Come Together доктор Аманда Кан объясняет, что современные стратегии долголетия работают не столько с внешними проявлениями старения, сколько с внутренними, на уровне клеток. Например, сейчас исследуются применение препаратов для снижения системного воспаления, улучшения работы митохондрий с помощью коэнзимов и гормональная оптимизация для сохранения мышечной массы, энергии и когнитивных функций. Эти методы работают как часть долгосрочной стратегии, а не как косметические процедуры.
5. Исследование, опубликованное в журнале Science Daily, показывает, что комбинация окситоцина и ингибитора рецептора TGF-β (Alk5) – это такое вещество, которое подавляет активность белка, связанного с возрастными изменениями и воспалением – может значительно продлить жизнь и улучшить здоровье очень пожилых самцов мышей. При этом речь идет не о профилактике, а о лечении уже возрастных изменений, что ближе к реальной клинической практике. Работа перспективна и для человеческого долголетия, потому что оба препарата уже существуют в медицине (один одобрен, другой тестируется), а значит, теоретически путь к клиническим испытаниям может быть быстрее, чем у новых экспериментальных молекул.
6. Исследование, которое провел Университет Восточной Финляндии, показало, что широта и качество социальных связей напрямую связаны с продолжительностью и качеством жизни пожилых людей. Ученые выяснили, что социальная поддержка влияет не только на психологическое состояние, но и на молекулярные маркеры старения, включая эпигенетические «часы» и уровень воспаления.
Эту неделю посвятим теме долголетия. Начинаем с нашего регулярного дайджеста инфоповодов, а также разберем, почему понятие «цикл жизни» уходит в прошлое, может ли биохакинг помочь предотвратить старение – и как нашему стремлению к молодости мешает ежедневный стресс.
1. Тренд на longevity (ставший главным в 2025 году по версии BoF) в следующем году будет только набирать обороты.
Акцент сместился с lifespan (цикл жизни) на healthspan (цикл здоровья) – годы, свободные от слабостей и болезней. Новая роскошь – это не дорогие вещи, а доступ к самой качественной медицине и новым технологиям.
Это подтверждают внушительные суммы инвестиций, которые в этой сфере в 2024 году достигли $8,5 млрд. При этом без вложений в долголетие увеличение продолжительности жизни может привести к негативным экономическим последствиям: важно не только сколько человек живет, но и насколько он может быть активным участником социума.
Так, например, только в США замедление процесса старения для увеличения ожидаемой продолжительности жизни на один год в сочетании со снижением заболеваемости принесет экономике $38 трлн.
2. На тренд активного долголетия отвечают и соцсети, в которых все чаще героями становятся пожилые люди. Так, 77-летняя Барбара «Babs» Костелло стала «любимой бабушкой TikTok»: у нее в подписчиках больше 8 млн человек. Она начала пользоваться соцсетями только в 72 года, а теперь ведет аккаунт, в котором делится бытовыми советами и философией здоровой зрелости: «Люди думают: "Мне 40, жизнь кончена". Какая чушь».
3. 55-летний биолог Гэри Брекка утверждает, биологический возраст можно изменить в лучшую сторону не только с помощью биохакинга, а привычным зожем. По его словам, его биологический возраст соответствует показателям 20-летнего человека. Формула Бреккка:
– здоровое питание,
– отсутствие стресса,
– физическая активность
– продуктивный сон.
Исследования, конечно, подтверждают влияние такого образа жизни на маркеры биологического возраста, но откатить возраст до молодости таким образом на самом деле вряд ли возможно
4. В подкасте Come Together доктор Аманда Кан объясняет, что современные стратегии долголетия работают не столько с внешними проявлениями старения, сколько с внутренними, на уровне клеток. Например, сейчас исследуются применение препаратов для снижения системного воспаления, улучшения работы митохондрий с помощью коэнзимов и гормональная оптимизация для сохранения мышечной массы, энергии и когнитивных функций. Эти методы работают как часть долгосрочной стратегии, а не как косметические процедуры.
5. Исследование, опубликованное в журнале Science Daily, показывает, что комбинация окситоцина и ингибитора рецептора TGF-β (Alk5) – это такое вещество, которое подавляет активность белка, связанного с возрастными изменениями и воспалением – может значительно продлить жизнь и улучшить здоровье очень пожилых самцов мышей. При этом речь идет не о профилактике, а о лечении уже возрастных изменений, что ближе к реальной клинической практике. Работа перспективна и для человеческого долголетия, потому что оба препарата уже существуют в медицине (один одобрен, другой тестируется), а значит, теоретически путь к клиническим испытаниям может быть быстрее, чем у новых экспериментальных молекул.
6. Исследование, которое провел Университет Восточной Финляндии, показало, что широта и качество социальных связей напрямую связаны с продолжительностью и качеством жизни пожилых людей. Ученые выяснили, что социальная поддержка влияет не только на психологическое состояние, но и на молекулярные маркеры старения, включая эпигенетические «часы» и уровень воспаления.
❤23
Почему селебрити могут стареть раньше
Слава может буквально «съедать» годы жизни музыкантов, говорится в свежем исследовании, которые провели ученые из Университета Виттен Гердеке, базирующегося в Виттене.
Авторы работы впервые смогли выделить именно фактор известности как независимый риск для здоровья: слава становится для многих музыкантов переломным моментом, после которого растут долгосрочные риски для здоровья. При этом речь не только о классических «рок-н-ролльных» факторах вроде алкоголя, запрещенных веществ, постоянных гастролей, но и о хроническом стрессе из-за потери приватности и эмоциональном выгорании, которые сопровождают публичную жизнь.
Особенно уязвимыми оказались сольные артисты – у них риск выше, чем у тех, кто выступает в составе группы и имеет постоянную поддержку коллег.
Слава может буквально «съедать» годы жизни музыкантов, говорится в свежем исследовании, которые провели ученые из Университета Виттен Гердеке, базирующегося в Виттене.
По их данным, знаменитые музыканты живут в среднем на 4–5 лет меньше, чем их менее известные коллеги. Средний возраст смерти у звезд составил около 75 лет, тогда как у артистов без статуса суперзвезды – почти 79.
Авторы работы впервые смогли выделить именно фактор известности как независимый риск для здоровья: слава становится для многих музыкантов переломным моментом, после которого растут долгосрочные риски для здоровья. При этом речь не только о классических «рок-н-ролльных» факторах вроде алкоголя, запрещенных веществ, постоянных гастролей, но и о хроническом стрессе из-за потери приватности и эмоциональном выгорании, которые сопровождают публичную жизнь.
«Повышенный риск смертности, связанный со славой, сопоставим с другими хорошо известными рисками для здоровья, такими как эпизодическое курение», – написали авторы.
Особенно уязвимыми оказались сольные артисты – у них риск выше, чем у тех, кто выступает в составе группы и имеет постоянную поддержку коллег.
❤11💯5👍3😱1
Самый простой «биохак» для долголетия может находиться буквально у вас под ногами – и это лестница
Обычный подъем по ступенькам оказался мощным маркером продолжительности жизни.
Сам факт, что человеку тяжело подниматься по лестнице, ученые сейчас воспринимают не как «мелкую бытовую проблему», а как ранний сигнал о системных сбоях в организме. Это может отражать снижение выносливости, мышечной силы и общего резерва здоровья. И наоборот, привычка подниматься по ступенькам регулярно связана с лучшей работой сердца, более крепкими мышцами и меньшим риском падений в пожилом возрасте.
Самое ценное в этом – доступность. Для лестницы не нужен ни абонемент, ни дополнительное время, но при этом с ее помощью можно дольше сохранять подвижность и здоровье.
Обычный подъем по ступенькам оказался мощным маркером продолжительности жизни.
Новые данные показывают: у людей, которые проходят примерно семь пролетов в неделю, снижается риск преждевременной смерти почти на 40% — особенно это важно для тех, у кого есть или может развиться остеоартрит колена.
Сам факт, что человеку тяжело подниматься по лестнице, ученые сейчас воспринимают не как «мелкую бытовую проблему», а как ранний сигнал о системных сбоях в организме. Это может отражать снижение выносливости, мышечной силы и общего резерва здоровья. И наоборот, привычка подниматься по ступенькам регулярно связана с лучшей работой сердца, более крепкими мышцами и меньшим риском падений в пожилом возрасте.
Самое ценное в этом – доступность. Для лестницы не нужен ни абонемент, ни дополнительное время, но при этом с ее помощью можно дольше сохранять подвижность и здоровье.
❤29🔥9😁1
Бодипозитив снова не в моде
Коллеги из «Антиглянца» обратили внимание на интервью Кейт Уинслет, в котором она жестко высказалась о стандартах красоты и том, как соцсети формируют зависимость от «идеальности»:
Чем больше распространяется «Оземпик», тем больше он становится «нормой»: почти никто не стесняется упоминать, что его принимает – в том числе и не по медицинским показаниям (мы писали об этом отдельно).
Естественность в целом не в моде: Крис Дженнер в свои 70 лет выглядит на 45 и благодарит за это хирургов, молодые звезды перестали скрывать, что делали пластические операции.
На место бодипозитива пришел старый добрый бодиперфекционизм, только на этот раз под соусом «осознанности» и «заботы о здоровье»: теперь мало быть просто худым (ведь это теперь всем доступно с помощью инъекций), надо быть mindfulness, как того требуют соцсети.
Коллеги из «Антиглянца» обратили внимание на интервью Кейт Уинслет, в котором она жестко высказалась о стандартах красоты и том, как соцсети формируют зависимость от «идеальности»:
«Если самооценка человека настолько зависит от внешности – это пугает. Они вообще знают, что вводят в свои тела? Это такое пренебрежение здоровьем. Это полный хаос. Я виню в таком влиянии на ментальное здоровье социальные сети», – возмущается актриса.
Чем больше распространяется «Оземпик», тем больше он становится «нормой»: почти никто не стесняется упоминать, что его принимает – в том числе и не по медицинским показаниям (мы писали об этом отдельно).
Естественность в целом не в моде: Крис Дженнер в свои 70 лет выглядит на 45 и благодарит за это хирургов, молодые звезды перестали скрывать, что делали пластические операции.
На место бодипозитива пришел старый добрый бодиперфекционизм, только на этот раз под соусом «осознанности» и «заботы о здоровье»: теперь мало быть просто худым (ведь это теперь всем доступно с помощью инъекций), надо быть mindfulness, как того требуют соцсети.
❤15🔥5💔4🎉2
Когда лишний бокал вина вызывает тревогу
Тема гибкого ЗОЖа была одной из самых популярных на прошедшей в сентябре конференции «Ко-Лаб». Мы обсуждали, почему классический ЗОЖ уже не работает как универсальный рецепт и где грань между пользой и безумием на пути к здоровью.
Эту же тему «Ко-Лаб» привез на большой медицинский конгресс «Экосистема здоровья как новая реальность, который прошел 9 декабря. Ее собрали по тому же принципу, по которому собран сам «Ко-Лаб»: в формате «врач-пациент», а не «врач-врач». Модерировала встречу автор YouTube-шоу БЕЗФИЛЬТРОВ, партнер «Ко-Лаб» Анастасия Полетаева.
На дискуссии в очередной раз подняли обсудили, как ЗОЖ стал культурной нормой. Люди стали тратить больше и требовать от себя тоже больше. Стало мало просто быть здоровым – индустрия превратилась в гонку за условными показателями на часах Whoop.
Отдельная тема – биохакинг. Из-за некоторых известных биохакеров, которые ставят весьма рискованные эксперименты над здоровьем (вроде «обмена плазмой» и вживления чипов), термин получил дурную славу. Но биохакинг – это скорее про превентивную медицину, и многие его методы пересекаются с ЗОЖ: это про понимание принципов работы организма, диета, измерение биомаркеров и так далее.
Современный гибкий ЗОЖ – это не набор правил, а пространство выбора. Возможность адаптировать практики под свой ритм жизни, слушать тело, а не тренды, и относиться к здоровью как к длительному процессу, а не марафону на выносливость.
Тема гибкого ЗОЖа была одной из самых популярных на прошедшей в сентябре конференции «Ко-Лаб». Мы обсуждали, почему классический ЗОЖ уже не работает как универсальный рецепт и где грань между пользой и безумием на пути к здоровью.
Эту же тему «Ко-Лаб» привез на большой медицинский конгресс «Экосистема здоровья как новая реальность, который прошел 9 декабря. Ее собрали по тому же принципу, по которому собран сам «Ко-Лаб»: в формате «врач-пациент», а не «врач-врач». Модерировала встречу автор YouTube-шоу БЕЗФИЛЬТРОВ, партнер «Ко-Лаб» Анастасия Полетаева.
На дискуссии в очередной раз подняли обсудили, как ЗОЖ стал культурной нормой. Люди стали тратить больше и требовать от себя тоже больше. Стало мало просто быть здоровым – индустрия превратилась в гонку за условными показателями на часах Whoop.
Сейчас все больше профессионалов пересматривают концепцию ЗОЖ и призывают искать баланс: выбирать поддерживающие практики, а не идеологию самосовершенствования, и фокусироваться на реальных потребностях – отдыхе, ментальном здоровье и эмоциональной устойчивости.
Отдельная тема – биохакинг. Из-за некоторых известных биохакеров, которые ставят весьма рискованные эксперименты над здоровьем (вроде «обмена плазмой» и вживления чипов), термин получил дурную славу. Но биохакинг – это скорее про превентивную медицину, и многие его методы пересекаются с ЗОЖ: это про понимание принципов работы организма, диета, измерение биомаркеров и так далее.
Современный гибкий ЗОЖ – это не набор правил, а пространство выбора. Возможность адаптировать практики под свой ритм жизни, слушать тело, а не тренды, и относиться к здоровью как к длительному процессу, а не марафону на выносливость.
❤16🔥2👍1
Физическая активность – один из самых мощных факторов продления жизни. Как и в остальных аспектах жизни главное здесь – регулярность и умеренность.
Разбираемся, как заниматься спортом так, чтобы в старости сказать себе спасибо, вместе с Эдуардом Безугловым, доцентом кафедры спортивной медицины и медицинской реабилитации Института клинической медицины им. Н.В. Склифосовского.
Разбираемся, как заниматься спортом так, чтобы в старости сказать себе спасибо, вместе с Эдуардом Безугловым, доцентом кафедры спортивной медицины и медицинской реабилитации Института клинической медицины им. Н.В. Склифосовского.
🔥12❤8
Эта неделя – самая темная в году. Как ее пережить?
Советы от скандинавских экспертов, рекомендации по питанию для хорошего настроения и подборка wellness-подарков – в нашем еженедельном дайджесте.
1. Темной зимой нужно использовать световые будильники и лампы для светотерапии, которые имитируют дневной свет и помогают «запустить» циркадные ритмы, советуют эксперты из Финляндии, Швеции и Норвегии. Такой свет способствует выработке серотонина, дает заряд бодрости и может облегчать симптомы сезонной депрессии.А еще есть базово-очевидный совет: не бороться с сезоном, а искать в нем свои плюсы: создать дома особенный уют, придумать особенные ритуалы, находить время для себя.
2. Кроме светотерапии жизнь облегчить могут… орехи! Исследователи из Южной Кореи выяснили, что люди, которые чаще едят орехи, в целом реже сталкиваются с депрессией – примерно на четверть по сравнению с теми, кто их не ест. Правда, чтобы добиться эффекта, орехи нужно есть не реже трех раз в неделю, а еще стоит помнить, что это только профилактика, а не лечение. Орехи богаты полезными жирами, витаминами и антиоксидантами, которые могут влиять на воспаление и процессы в мозге, связанные с настроением.
3. Темная неделя совпадает еще и с сезоном простуд, поэтому в Guardian задались вопросом, действительно ли витамин С помогает реже болеть. Оказалось, что научные данные это не подтверждают: максимум, на что может повлиять витамин C, – это немного сократить длительность симптомов, примерно на 8% у взрослых, и то эффект считается довольно скромным. А поддержать иммунитет скорее поможет витамин D.
4. А теперь внимание: люди, которые регулярно недосыпают, в среднем живут меньше, показало свежее исследование американских ученых. Даже если человек не курит, нормально питается и занимается спортом, недостаток сна все равно сказывается на продолжительности жизни. То есть сон сам по себе – очень важный фактор для здоровья и долголетия. Даже малоподвижный образ жизни и плохой рацион – не так страшны, как недосып.
5. Ну и напоследок, к приятному: в преддверие новогодних праздников Harper Bazaar подготовил список подарков в категории wellness. Вдохновляемся и настраиваемся на счастливые каникулы. Осталось еще чуть-чуть.
Советы от скандинавских экспертов, рекомендации по питанию для хорошего настроения и подборка wellness-подарков – в нашем еженедельном дайджесте.
1. Темной зимой нужно использовать световые будильники и лампы для светотерапии, которые имитируют дневной свет и помогают «запустить» циркадные ритмы, советуют эксперты из Финляндии, Швеции и Норвегии. Такой свет способствует выработке серотонина, дает заряд бодрости и может облегчать симптомы сезонной депрессии.
2. Кроме светотерапии жизнь облегчить могут… орехи! Исследователи из Южной Кореи выяснили, что люди, которые чаще едят орехи, в целом реже сталкиваются с депрессией – примерно на четверть по сравнению с теми, кто их не ест. Правда, чтобы добиться эффекта, орехи нужно есть не реже трех раз в неделю, а еще стоит помнить, что это только профилактика, а не лечение. Орехи богаты полезными жирами, витаминами и антиоксидантами, которые могут влиять на воспаление и процессы в мозге, связанные с настроением.
3. Темная неделя совпадает еще и с сезоном простуд, поэтому в Guardian задались вопросом, действительно ли витамин С помогает реже болеть. Оказалось, что научные данные это не подтверждают: максимум, на что может повлиять витамин C, – это немного сократить длительность симптомов, примерно на 8% у взрослых, и то эффект считается довольно скромным. А поддержать иммунитет скорее поможет витамин D.
4. А теперь внимание: люди, которые регулярно недосыпают, в среднем живут меньше, показало свежее исследование американских ученых. Даже если человек не курит, нормально питается и занимается спортом, недостаток сна все равно сказывается на продолжительности жизни. То есть сон сам по себе – очень важный фактор для здоровья и долголетия. Даже малоподвижный образ жизни и плохой рацион – не так страшны, как недосып.
5. Ну и напоследок, к приятному: в преддверие новогодних праздников Harper Bazaar подготовил список подарков в категории wellness. Вдохновляемся и настраиваемся на счастливые каникулы. Осталось еще чуть-чуть.
❤11🤯4👍3
SAD – это не грустный
Сезонное аффективное расстройство (SAD) – это не просто «плохое настроение зимой», а форма депрессии, напрямую связанная с сокращением светового дня. Чаще всего симптомы появляются осенью и зимой и проходят весной, когда становится больше естественного света.
Из-за этого человек может чувствовать постоянную усталость, раздражительность, апатию, тянуться к сладкому и углеводам, больше спать, но не чувствовать себя отдохнувшим. Знакомо? Знакомо!
Эти симптомы похожи на обычную депрессию, но ключевое отличие – их сезонность. Именно свет играет здесь решающую роль: исследования показывают, что у людей с SAD сетчатка может быть менее чувствительна к свету, а значит, мозг хуже получает сигнал о том, что «день начался». В итоге внутренние часы как будто отстают, а тело живет в режиме вечного сумеречного утра.
Сезонное аффективное расстройство (SAD) – это не просто «плохое настроение зимой», а форма депрессии, напрямую связанная с сокращением светового дня. Чаще всего симптомы появляются осенью и зимой и проходят весной, когда становится больше естественного света.
По разным оценкам, с этим состоянием сталкиваются до 10% людей. Основная идея, на которой сходятся исследователи, в том, что недостаток света сбивает наши биологические часы: нарушается циркадный ритм, дольше вырабатывается мелатонин – гормон сна, а уровень серотонина, который связан с настроением и энергией, снижается.
Из-за этого человек может чувствовать постоянную усталость, раздражительность, апатию, тянуться к сладкому и углеводам, больше спать, но не чувствовать себя отдохнувшим. Знакомо? Знакомо!
Эти симптомы похожи на обычную депрессию, но ключевое отличие – их сезонность. Именно свет играет здесь решающую роль: исследования показывают, что у людей с SAD сетчатка может быть менее чувствительна к свету, а значит, мозг хуже получает сигнал о том, что «день начался». В итоге внутренние часы как будто отстают, а тело живет в режиме вечного сумеречного утра.
❤11👌6🔥2
Если в декабре еще нужны доводы в пользу медитаций, то вот они. Объясняет Наталья Османн, одна из самых влиятельных тревел-инфлюенсеров мира и основательница йога-студии Ashram.
❤14🔥6👍2